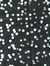
48521927

Chris Tonelli
Goodreads Author
Member Since
May 2007
|
The Trees Around
—
published
2010
|
|
|
Whatever Stasis
—
published
2018
|
|
|
WIDE TREE: Short Poems
—
published
2006
|
|
|
No Theater
—
published
2009
—
2 editions
|
|
|
For People Who Like Gravity and Other People
—
published
2010
|
|
|
INCREMENT
—
published
2013
|
|
|
Voices Found: Free Jazz and Singing
|
|
|
Voices Found: Free Jazz and Singing
|
|
|
Voices Found: Free Jazz and Singing
|
|
|
Wide Tree Short Poems
|
|
Chris’s Recent Updates
|
Chris
rated a book it was amazing
|
|
| Equal parts historical fiction, love story, crime novel, and bildungsroman, Kovach’s The Closing Days reminds us why we cherish great novels—adventure, romance, human intimacies and peculiarities, universal truths, triumphs and foibles. With effortle ...more | |
|
Chris
is now following
|
|
Black Oceanographers
— 237 members
— last activity Dec 14, 2010 12:38PM
This group is designed to discuss books published by Black Ocean, receive updates on publications and get news on author events. All are welcome, only ...more
Q&A with Paulo Coelho
— 1031 members
— last activity Jul 24, 2022 03:41AM
Goodreads Author Paulo Coelho will be available February 15 - 29, 2008 to answer questions. MESSAGE FROM THE AUTHOR: Dear readers, it's a pleasure m ...more
¡ POETRY !
— 22521 members
— last activity May 24, 2026 04:09PM
No pretensions: just poetry. Stop by, recommend books, offer up poems (excerpted), tempt us, taunt us, tell us what to read and where to go (to read ...more
New York Quarterly
— 19 members
— last activity Feb 18, 2009 09:29PM
The New York Quarterly was established in 1969 by the late William Packard out of a growing concern for the pure craft and technique of poetry writing ...more
Scantily Clad Press
— 181 members
— last activity Jul 13, 2016 06:22AM
SCP is an e-chap series edited by Andrew Lundwall. . .
NYQ Books
— 21 members
— last activity Jul 11, 2016 07:14AM
NYQ Books is an imprint of The New York Quarterly Foundation, Inc., a 501c3 non-profit dedicated to bringing poetry to the forefront of society.